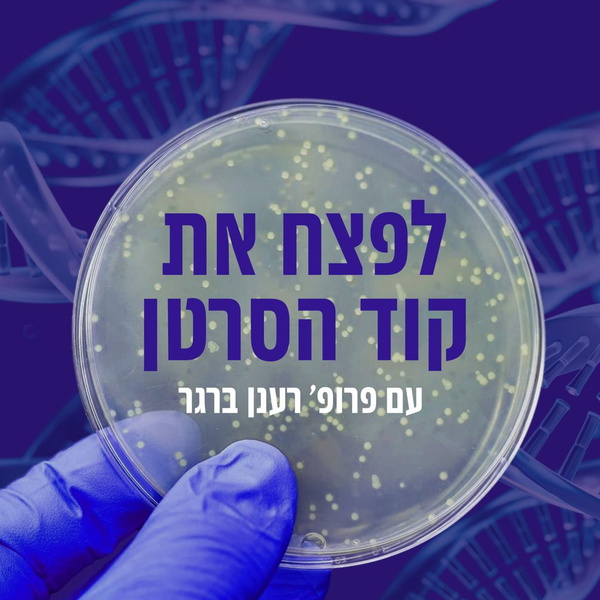

Medicine Podcasts - Apple Podcasts -  Israel
Israel
View the podcast rankings for Israel in the Apple Podcasts charts. Rephonic updates this list of top medicine podcasts daily and gives you access to listener numbers, contacts, social media accounts and more.
What are the best medicine podcasts in Israel?
Rephonic presents these charts featuring the best medicine podcasts in Israel, sourced directly from Apple Podcasts. By tapping on a podcast you can delve into a wealth of information, including listener numbers, social reach, engagement scores, and lots more.
What are the most popular medicine podcasts in Israel?
Discover the most popular medicine podcasts in Israel through these comprehensive charts by Apple Podcasts. With Rephonic you can delve deeper into essential popularity metrics, such as listener numbers, social reach, reviews and ratings.
What are the most listened to medicine podcasts in Israel?
Explore some of the most listened to medicine podcasts in Israel through these charts. Uncover the podcast rankings from Apple Podcasts and find out how many listeners each show has with Rephonic. Compare other stats by tapping on a show.
Where can I find the top medicine podcasts in Israel?
Rephonic lists the top medicine podcasts in Israel to help you decide which shows to pitch as a guest or sponsor. View tons of invaluable data including listener numbers, social reach, reviews and more. Make better-informed decisions.